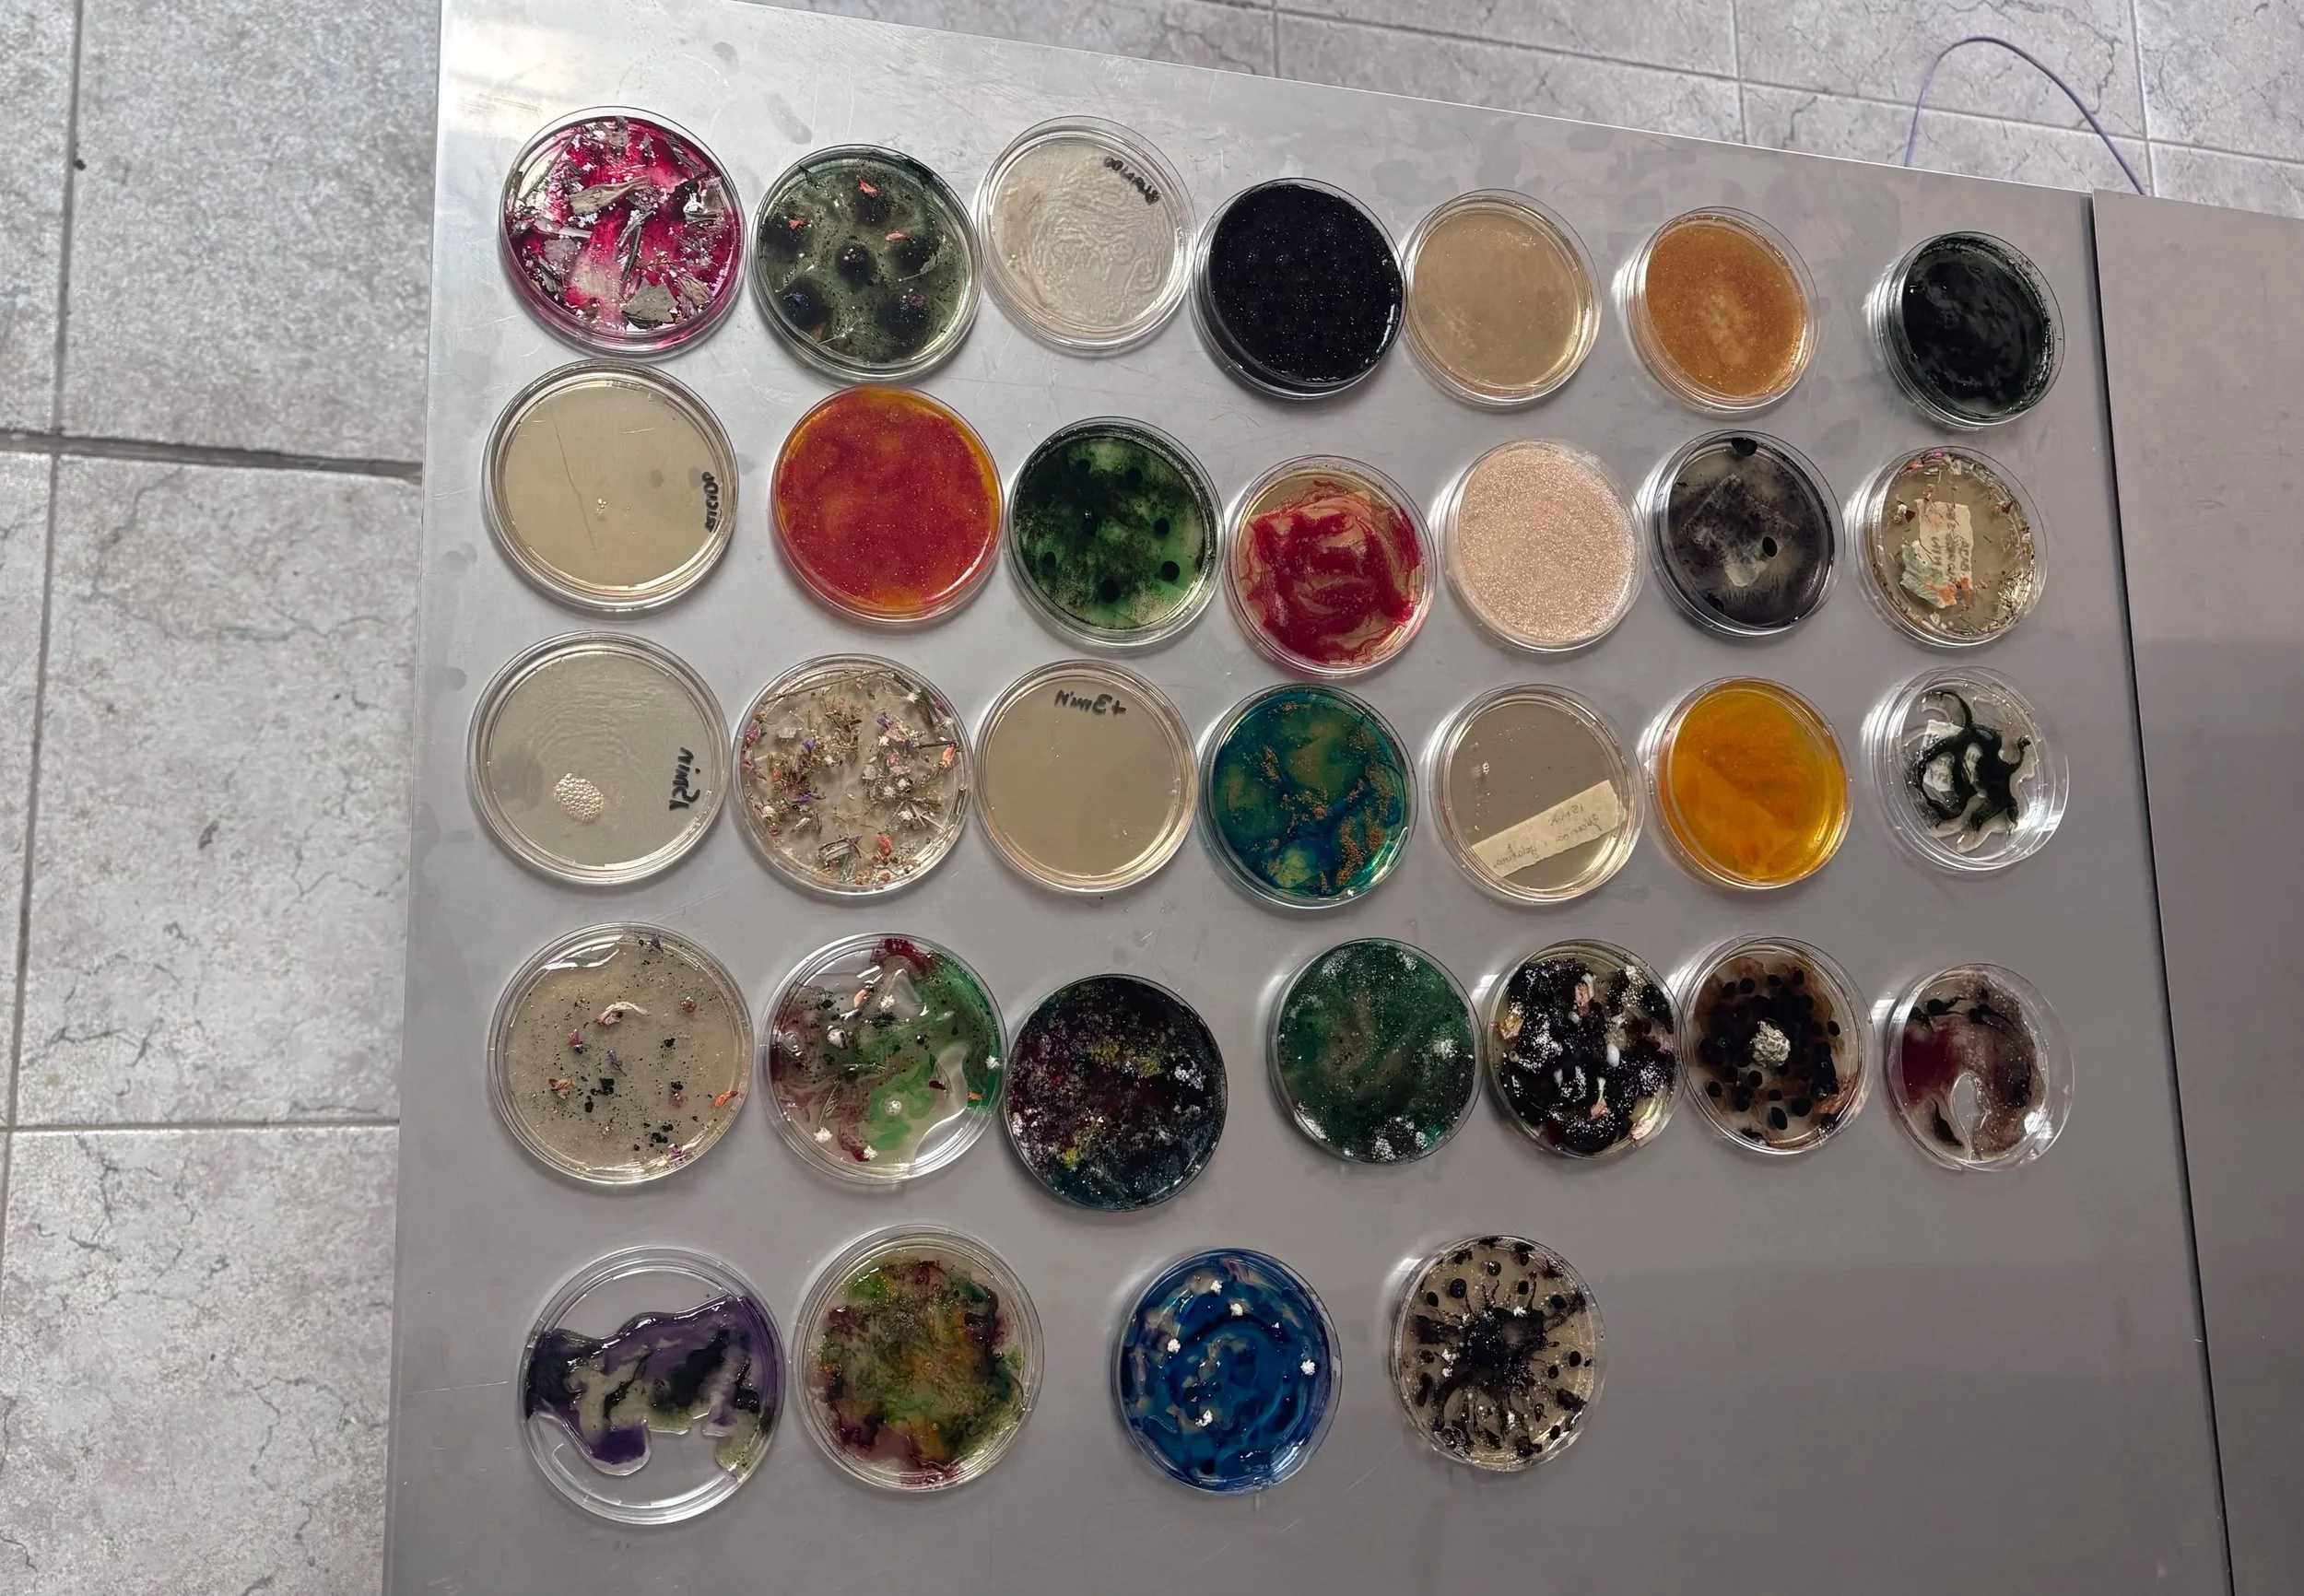

* JANUARY ONLINE LIVE WORKSHOPS *
Learn all about Biomaterials 🧫 in a live class with others 🔀
This is for everyone who can’t come to in-person workshops but wants a similar experience!
AVAILABLE CLASSES:
Algae Yarn Workshop
→ Learn how to make Yarn from Algae and how to knit or crochet with it
Bioplastic Workshop
→ Learn how to make experimental Bioplastic (hard or flexible/ transparent or colourful)
Bio-Leather with Food Waste Workshop
→ Learn how to make a Leather Alternative with Food Waste from your kitchen residues
*All classes are in the Paris/Berlin Timezone — please check and see what time this would mean for your location!
SIGN UP HERE ⬇️
Booking closes on the 30th of december ❕
Please note that all prices do not include materials. Once signed up, you will receive a comprehensive list of all materials you need to purchase (usually around 30€ extra, depending on the class). The advantage is that you will have all the necessary equipment ready for continuing your practice after the class.
Please also respect that I am not able to share the material list beforehand — after receiving the ‘shopping list’, you can check in with me for any questions.
Due to the shipment time of some products, all sign-ups end 2 weeks before the classes start. The earlier you sign up, the better you can plan and start preparing for the class and your practice afterwards.
Looking forward to meeting and creating Biomaterials with all of you very soon!
*Please note that once you have registered, cancellations are no longer possible. This is because, upon registration, you immediately receive the material list and recipe, meaning the transfer of information has already begun. We strongly encourage you to attend the class live. However, suppose you are unable to participate on the scheduled day due to illness or an emergency. In that case, you will still receive the class recording and presentation materials, allowing you to learn the process at your own pace.

